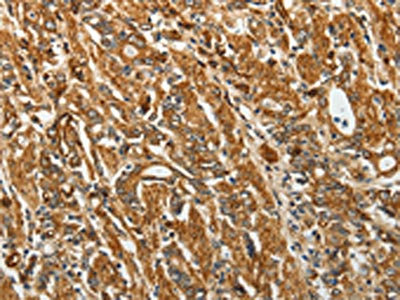

RPLP0 Antibody
-
中文名稱(chēng):RPLP0兔多克隆抗體
-
貨號(hào):CSB-PA043719
-
規(guī)格:¥1100
-
圖片:
-
The image on the left is immunohistochemistry of paraffin-embedded Human gastic cancer tissue using CSB-PA043719(RPLP0 Antibody) at dilution 1/40, on the right is treated with fusion protein. (Original magnification: ×200)
-
The image on the left is immunohistochemistry of paraffin-embedded Human ovarian cancer tissue using CSB-PA043719(RPLP0 Antibody) at dilution 1/40, on the right is treated with fusion protein. (Original magnification: ×200)
-
Gel: 10%SDS-PAGE, Lysate: 40 μg, Lane 1-3: NIH/3T3 cells, A431 cells, Jurkat cells, Primary antibody: CSB-PA043719(RPLP0 Antibody) at dilution 1/750, Secondary antibody: Goat anti rabbit IgG at 1/8000 dilution, Exposure time: 1 minute
-
-
其他:
產(chǎn)品詳情
-
Uniprot No.:
-
基因名:RPLP0
-
別名:36B4 antibody; 60S acidic ribosomal protein P0 antibody; 60S ribosomal protein L10E antibody; Acidic ribosomal phosphoprotein P0 antibody; Arbp antibody; L10E antibody; LP0 antibody; MGC107165 antibody; MGC107166 antibody; MGC111226 antibody; MGC88175 antibody; OTTMUSP00000015585 antibody; P0 antibody; PRLP0 antibody; Ribosomal phosphoprotein; acidic; P0 antibody; Ribosomal protein P0 antibody; Ribosomal protein; large; P0 antibody; RLA0_HUMAN antibody; rplP0 antibody; RPP0 antibody
-
宿主:Rabbit
-
反應(yīng)種屬:Human,Mouse,Rat
-
免疫原:Fusion protein of Human RPLP0
-
免疫原種屬:Homo sapiens (Human)
-
標(biāo)記方式:Non-conjugated
-
抗體亞型:IgG
-
純化方式:Antigen affinity purification
-
濃度:It differs from different batches. Please contact us to confirm it.
-
保存緩沖液:-20°C, pH7.4 PBS, 0.05% NaN3, 40% Glycerol
-
產(chǎn)品提供形式:Liquid
-
應(yīng)用范圍:ELISA,WB,IHC
-
推薦稀釋比:
Application Recommended Dilution ELISA 1:2000-1:5000 WB 1:500-1:2000 IHC 1:50-1:200 -
Protocols:
-
儲(chǔ)存條件:Upon receipt, store at -20°C or -80°C. Avoid repeated freeze.
-
貨期:Basically, we can dispatch the products out in 1-3 working days after receiving your orders. Delivery time maybe differs from different purchasing way or location, please kindly consult your local distributors for specific delivery time.
-
用途:For Research Use Only. Not for use in diagnostic or therapeutic procedures.
相關(guān)產(chǎn)品
靶點(diǎn)詳情
-
功能:Ribosomal protein P0 is the functional equivalent of E.coli protein L10.
-
基因功能參考文獻(xiàn):
- The presence of uL10 on the ribosomes is affected in stressed cells, thus it might be considered as a regulatory element responding to environmental fluctuations. PMID: 28986221
- absence of RPLP0, RPLP1, or RPLP2 resulted in reactive oxygen species (ROS) accumulation and MAPK1/ERK2 signaling pathway activation. PMID: 26176264
- This study shows a spontaneous humoral immune response to ribosomal P0 protein in colorectal cancer patients. PMID: 25889931
- Down-regulation of RPLP0 resulted in G1 arrest of gastric cancer cells PMID: 25433997
- the immune response mediated by serum anti-RPLP0 and anti-galectin 3 antibodies plays a key role in the pathogenesis of SLE skin lesions. These findings provide new insights into the mechanism of SLE-related organ disorders. PMID: 25307291
- Evaluated autoantibodies against native ribosomal P complex and recombinant ribosomal P proteins (anti-Rib-P0, anti-Rib-P1, anti-Rib-P2) for prevalence, diagnostic relevance&clinical associations in a Chinese cohort with systemic lupus erythematosus. PMID: 23400861
- P proteins are up-regulated in a considerable number of patients with the most common types of cancer. PMID: 21040949
- The P0 protein was found in the cytoplasm, as well as in the nucleus; however, the nucleoli were excluded. This protein was scattered around the nuclei, and the distribution might reflect association with the so-called nuclear bodies PMID: 12479870
- Recombinant fusion protein GST.P0 expressed in insect cells, but not the protein obtained in Escherichia coli, had the ability to form a complex with P1 and P2 proteins. PMID: 15336536
- P0 overexpression may cause tumorigenesis in breast and liver tissues at least in part by inhibiting GCIP-mediated tumor suppression. PMID: 17621266
顯示更多
收起更多
-
亞細(xì)胞定位:Nucleus. Cytoplasm.
-
蛋白家族:Universal ribosomal protein uL10 family
-
數(shù)據(jù)庫(kù)鏈接:
Most popular with customers
-
-
YWHAB Recombinant Monoclonal Antibody
Applications: ELISA, WB, IHC, IF, FC
Species Reactivity: Human, Mouse, Rat
-
Phospho-YAP1 (S127) Recombinant Monoclonal Antibody
Applications: ELISA, WB, IHC
Species Reactivity: Human
-
-
-
-
-